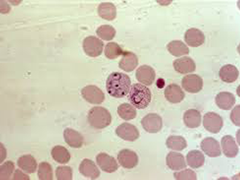

Serology
Serology is the scientific study of serum and other bodily fluids, referring to the diagnostic identification of antibodies in the serum. Many antibodies are typically formed in response to an infection (against a given microorganism), against other foreign proteins (in response, for example, to a mismatched blood transfusion), or to one's own proteins (in instances of autoimmune disease). Identification of various blood groups or appearance of new biomarkers in body fluids can be detected using glycan-specific lectins.